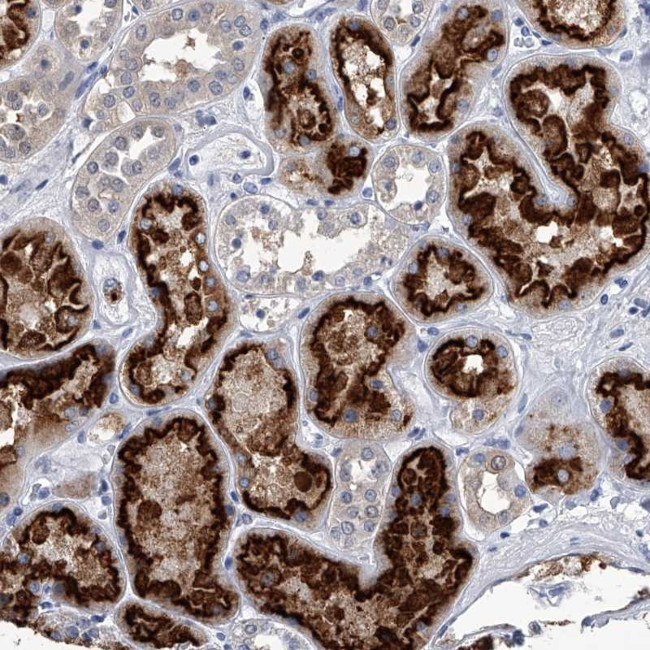
PDXK Antibody in Immunohistochemistry (Paraffin) (IHC (P))

Search
Invitrogen
PDXK Polyclonal Antibody
{{$productOrderCtrl.translations['antibody.pdp.commerceCard.promotion.promotions']}}
{{$productOrderCtrl.translations['antibody.pdp.commerceCard.promotion.viewpromo']}}
{{$productOrderCtrl.translations['antibody.pdp.commerceCard.promotion.promocode']}}: {{promo.promoCode}} {{promo.promoTitle}} {{promo.promoDescription}}. {{$productOrderCtrl.translations['antibody.pdp.commerceCard.promotion.learnmore']}}
产品信息
PA5-56395
种属反应
宿主/亚型
分类
类型
抗原
偶联物
形式
浓度
规格
纯化类型
保存液
内含物
保存条件
运输条件
RRID
产品详细信息
Immunogen sequence: FSNHTGYAHW KGQVLNSDEL QELYEGLRLN NMNKYDYVLT GYTRDKSFLA MVVDIVQELK QQNPRLVYVC DPVLGDKWDG EGSMYVPE
Highest antigen sequence identity to the following orthologs: Mouse - 86%, Rat - 85%.
靶标信息
Pyridoxal kinase (PDXK) converts vitamin B6 to pyridoxal-5-phosphate (PLP), an essential cofactor in the intermediate metabolism of amino acids and neurotransmitters. The PDXK gene encodes a 312-amino acid polypeptide, and expression of the cDNA reveals pyridoxal kinase activity. Northern blot analysis revealed that a major 1.5-kb PDXK transcript is expressed in all tissues tested. The expression of PDXK shows circadian oscillations. The expression of Pdxk in mouse liver and brain is regulated by the 3 PAR bZIP transcription factors, Dbp, Hlf, and Tef, which also show circadian oscillations in expression. Mice devoid of all 3 transcription factors show decreased levels of brain PLP, serotonin, and dopamine, and are highly susceptible to frequently lethal generalized spontaneous and audiogenic epilepsies.
仅用于科研。不用于诊断过程。未经明确授权不得转售。
篇参考文献 (0)
生物信息学
蛋白别名: epididymis secretory sperm binding protein Li 1a; pyridoxal (pyridoxine, vitamin B6) kinase; Pyridoxal kinase; pyridoxamine kinase; Pyridoxine kinase; pyridoxine; vitamin B6; unnamed protein product; vitamin B6 kinase
基因别名: C21orf124; C21orf97; HEL-S-1a; HMSN6C; PDXK; PKH; PNK; PRED79
UniProt ID: (Human) O00764
Entrez Gene ID: (Human) 8566